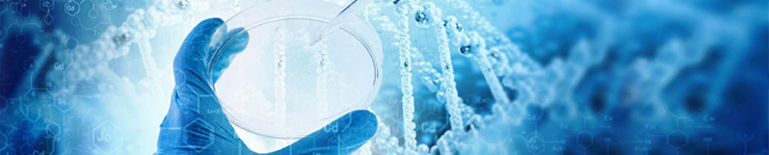
Nauka.

Działalność naukowa:
Topoizomerazy jako cele molekularne nowych pochodnych leków przeciwnowotworowych.
Właściwości biologiczne nowych proleków przeciwnowotworowych.
Wpływ nowych leków przeciwnowotworowych na procesy apoptozy i przekaźnictwa sygnałowego w komórkach raka piersi.
Nanocząstki jako strategia w projektowaniu nowych leków.
Przeciwciała monoklonalne w terapii przeciwnowotworowej.
Zastosowanie komórek macierzystych w terapii przeciwnowotworowej oraz w kosmetologii.
Realizowane projekty badawcze:
- projekt Narodowej Agencji Wymiany Akademickiej w ramach programu "Partnerstwa strategicznego" pt. Przeciwciała monoklonalne w skojarzeniu z analogami tiazolidynonu jako nowoczesna strategia przeciwnowotworowa"
- projekt statutowy UMB pt. Poszukiwanie nowych analogów tiazolidynonów o działaniu przeciwnowotworowym.
- projekt statutowy UMB pt. Wpływ nowych pochodnych tiazolidynonu na indukcję apoptozy w komórkach białaczek ludzkich.
- projekt statutowy UMB pt. Wpływ skojarzonego działania nowej pochodnej tiazolidynonu z trastuzumabem i pertuzumabem na proces przekaźnictwa sygnałowego w komórkach raka żołądka AGS.
- projekt statutowy UMB pt. Projektowanie, synteza oraz badania molekularnego mechanizmu działania przeciwnowotworowego nowych pochodnych kwasu ursolowego.
Współpraca naukowa z jednostkami w kraju:
- Instytut Chemii Organicznej PAN w Warszawie
- Uniwersytet Medyczny w Lublinie
- Uniwersytet w Białymstoku
- Uniwersytet Jagielloński w Krakowie
- Politechnika Gdańska
- Politechnika Warszawska
- Uniwersytet Przyrodniczo-Humanistyczny w Siedlcach
- Instytut Farmaceutyczny w Warszawie
- Sieć Badawcza Łukasiewicz – Instytut Chemii Przemysłowej w Warszawie
Współpraca naukowa z jednostkami za granicą:
- Department of Chemistry Brooklyn College The City University of New York, USA
- Department of Pharmaceutical, Organic and Bioorganic Chemistry, Danylo Halytsky Lviv National Medical University, Lviv, Ukraine
- Chromatin Dynamics and Metabolism in Cancer, CNRS UMR9018, Gustave Roussy, Villejuif, France
Stosowane techniki:
- spektroskopia UV/VIS
- spektrofluorymetria
- cytometria przepływowa
- nanokalorymetria ITC i DSC
- western immunoblot
- technika immunoenzymatyczna - ELISA
Publikacje:
Szewczyk-Roszczenko, O. K., Roszczenko, P., Shmakova, A., Yushyn, I., Holota, S., Karpenko, O., Czarnomysy, R., Bielawska, A., Vassetzky, Y., Lesyk, R., & Bielawski, K. (2025). Novel endocytosis inhibitors block entry of HIV-1 Tat into neural cells. American journal of physiology. Cell physiology, 328(2), C404–C413. https://doi.org/10.1152/ajpcell.00723.2024
Szymanowska, A., Radomska, D., Czarnomysy, R., Mojzych, M., Kotwica-Mojzych, K., Bielawski, K., & Bielawska, A. (2024). The activity of pyrazolo[4,3-e][1,2,4]triazine and pyrazolo[4,3-e]tetrazolo[1,5-b][1,2,4]triazine sulphonamide derivatives in monolayer and spheroid breast cancer cell cultures. Journal of enzyme inhibition and medicinal chemistry, 39(1), 2343352. https://doi.org/10.1080/14756366.2024.2343352
Zakrzewski M, Gornowicz A, Zakrzewska M, Bielawska A, Maciorkowska E. Selected Markers of Inflammation in the Saliva of Children Infected with Helicobacter pylori. Int J Mol Sci. 2024;25(23):12780. Published 2024 Nov 28. doi:10.3390/ijms252312780
Roszczenko, P., Szewczyk-Roszczenko, O. K., Gornowicz, A., Czarnomysy, R., Lozynskyi, A., Bielawski, K., Lesyk, R., & Bielawska, A. (2024). Trastuzumab Potentiates Antitumor Activity of Thiopyrano[2,3-d]Thiazole Derivative in AGS Gastric Cancer Cells. Molecules (Basel, Switzerland), 29(21), 5117. https://doi.org/10.3390/molecules29215117
Roszczenko, P., Szewczyk-Roszczenko, O. K., Gornowicz, A., Iwańska, I. A., Bielawski, K., Wujec, M., & Bielawska, A. (2024). The Anticancer Potential of Edible Mushrooms: A Review of Selected Species from Roztocze, Poland. Nutrients, 16(17), 2849. https://doi.org/10.3390/nu16172849
Finiuk, N., Kozak, Y., Gornowicz, A., Czarnomysy, R., Tynecka, M., Holota, S., Moniuszko, M., Stoika, R., Lesyk, R., Bielawski, K., & Bielawska, A. (2024). The Proapoptotic Action of Pyrrolidinedione-Thiazolidinone Hybrids towards Human Breast Carcinoma Cells Does Not Depend on Their Genotype. Cancers, 16(16), 2924. https://doi.org/10.3390/cancers16162924
Radomska, D., Czarnomysy, R., Szymanowska, A., Radomski, D., Chalecka, M., Surazynski, A., Domínguez-Álvarez, E., Bielawska, A., & Bielawski, K. (2024). Di- and Triselenoesters-Promising Drug Candidates for the Future Therapy of Triple-Negative Breast Cancer. International journal of molecular sciences, 25(14), 7764. https://doi.org/10.3390/ijms25147764
Podolak, M., Holota, S., Deyak, Y., Dziduch, K., Dudchak, R., Wujec, M., Bielawski, K., Lesyk, R., & Bielawska, A. (2024). Tubulin inhibitors. Selected scaffolds and main trends in the design of novel anticancer and antiparasitic agents. Bioorganic chemistry, 143, 107076. https://doi.org/10.1016/j.bioorg.2023.107076
Dudchak, R., Podolak, M., Holota, S., Szewczyk-Roszczenko, O., Roszczenko, P., Bielawska, A., Lesyk, R., & Bielawski, K. (2024). Click chemistry in the synthesis of antibody-drug conjugates. Bioorganic chemistry, 143, 106982. https://doi.org/10.1016/j.bioorg.2023.106982
Szymanowski W, Szymanowska A, Bielawska A, Lopez-Berestein G, Rodriguez-Aguayo C, Amero P. Aptamers as Potential Therapeutic Tools for Ovarian Cancer: Advancements and Challenges. Cancers (Basel). 2023;15(21):5300. Published 2023 Nov 6. doi:10.3390/cancers15215300
Kopystecka A, Kozioł I, Radomska D, Bielawski K, Bielawska A, Wujec M. Vaccinium uliginosum and Vaccinium myrtillus-Two Species-One Used as a Functional Food. Nutrients. 2023;15(19):4119. Published 2023 Sep 23. doi:10.3390/nu15194119
Szewczyk-Roszczenko, O. K., Roszczenko, P., Shmakova, A., Finiuk, N., Holota, S., Lesyk, R., Bielawska, A., Vassetzky, Y., & Bielawski, K. (2023). The Chemical Inhibitors of Endocytosis: From Mechanisms to Potential Clinical Applications. Cells, 12(18), 2312. https://doi.org/10.3390/cells12182312
Gornowicz A, Lesyk R, Czarnomysy R, Holota S, Shepeta Y, Popławska B, Podolak M, Szymanowski W, Bielawski K, Bielawska A. Multi-Targeting Anticancer Activity of a New 4-Thiazolidinone Derivative with Anti-HER2 Antibodies in Human AGS Gastric Cancer Cells. Int J Mol Sci. 2023 Apr 5;24(7):6791. doi: 10.3390/ijms24076791. PMID: 37047765; PMCID: PMC10095353.
Ivasechko I, Lozynskyi A, Senkiv J, Roszczenko P, Kozak Y, Finiuk N, Klyuchivska O, Kashchak N, Manko N, Maslyak Z, Lesyk D, Karkhut A, Polovkovych S, Czarnomysy R, Szewczyk O, Kozytskiy A, Karpenko O, Khyluk D, Gzella A, Bielawski K, Bielawska A, Dzubak P, Gurska S, Hajduch M, Stoika R, Lesyk R. Molecular design, synthesis and anticancer activity of new thiopyrano[2,3-d]thiazoles based on 5-hydroxy-1,4-naphthoquinone (juglone). Eur J Med Chem. 2023 Apr 5;252:115304. doi: 10.1016/j.ejmech.2023.115304. Epub 2023 Mar 24. PMID: 37001390.
Zyśk B, Ostrowska L, Smarkusz-Zarzecka J, Witczak-Sawczuk K, Gornowicz A, Bielawska A. Pro-Inflammatory Adipokine and Cytokine Profiles in the Saliva of Obese Patients with Non-Alcoholic Fatty Liver Disease (NAFLD)-A Pilot Study. Int J Mol Sci. 2023 Feb 2;24(3):2891. doi: 10.3390/ijms24032891. PMID: 36769216; PMCID: PMC9917694.
Roszczenko P, Holota S, Szewczyk OK, Dudchak R, Bielawski K, Bielawska A, Lesyk R. 4-Thiazolidinone-Bearing Hybrid Molecules in Anticancer Drug Design. Int J Mol Sci. 2022 Oct 28;23(21):13135. doi: 10.3390/ijms232113135. PMID: 36361924.
Roszczenko P, Szewczyk OK, Czarnomysy R, Bielawski K, Bielawska A. Biosynthesized Gold, Silver, Palladium, Platinum, Copper, and Other Transition Metal Nanoparticles. Pharmaceutics. 2022 Oct 25;14(11):2286. doi: 10.3390/pharmaceutics14112286. PMID: 36365105.
Janowska S, Khylyuk D, Gornowicz A, Bielawska A, Janowski M, Czarnomysy R, Bielawski K, Wujec M. Synthesis and Anticancer Activity of 1,3,4-Thiadiazoles with 3-Methoxyphenyl Substituent. Molecules. 2022 Oct 17;27(20):6977. doi: 10.3390/molecules27206977. PMID: 36296570; PMCID: PMC9607157.
Lendzion K, Gornowicz A, Strawa JW, Bielawska K, Czarnomysy R, Popławska B, Bielawski K, Tomczyk M, Miltyk W, Bielawska A. LC-PDA-MS and GC-MS Analysis of Scorzonera hispanica Seeds and Their Effects on Human Breast Cancer Cell Lines. Int J Mol Sci. 2022 Sep 30;23(19):11584. doi: 10.3390/ijms231911584. PMID: 36232888; PMCID: PMC9569732.
Ivasechko I, Yushyn I, Roszczenko P, Senkiv J, Finiuk N, Lesyk D, Holota S, Czarnomysy R, Klyuchivska O, Khyluk D, Kashchak N, Gzella A, Bielawski K, Bielawska A, Stoika R, Lesyk R. Development of Novel Pyridine-Thiazole Hybrid Molecules as Potential Anticancer Agents. Molecules. 2022 Sep 21;27(19):6219. doi: 10.3390/molecules27196219. PMID: 36234755; PMCID: PMC9570594.
Radomska D, Czarnomysy R, Szymanowska A, Radomski D, Domínguez-Álvarez E, Bielawska A, Bielawski K. Novel Selenoesters as a Potential Tool in Triple-Negative Breast Cancer Treatment. Cancers (Basel). 2022 Sep 2;14(17):4304. doi: 10.3390/cancers14174304. PMID: 36077839; PMCID: PMC9454901.
Radziejewska I, Supruniuk K, Tomczyk M, Izdebska W, Borzym-Kluczyk M, Bielawska A, Bielawski K, Galicka A. p-Coumaric acid, Kaempferol, Astragalin and Tiliroside Influence the Expression of Glycoforms in AGS Gastric Cancer Cells. Int J Mol Sci. 2022 Aug 2;23(15):8602. doi: 10.3390/ijms23158602. PMID: 35955735; PMCID: PMC9369150.
Szewczyk OK, Roszczenko P, Czarnomysy R, Bielawska A, Bielawski K. An Overview of the Importance of Transition-Metal Nanoparticles in Cancer Research. Int J Mol Sci. 2022 Jun 15;23(12):6688. doi: 10.3390/ijms23126688. PMID: 35743130; PMCID: PMC9223356.
Buzun K, Gornowicz A, Lesyk R, Kryshchyshyn-Dylevych A, Gzella A, Czarnomysy R, Latacz G, Olejarz-Maciej A, Handzlik J, Bielawski K, Bielawska A. 2-{5-[(Z,2Z)-2-Chloro-3-(4-nitrophenyl)-2-propenylidene]-4-oxo-2-thioxothiazolidin-3-yl}-3-methylbutanoic Acid as a Potential Anti-Breast Cancer Molecule. Int J Mol Sci. 2022 Apr 7;23(8):4091. doi: 10.3390/ijms23084091. PMID: 35456915; PMCID: PMC9032233.
Janowska S, Khylyuk D, Bielawska A, Szymanowska A, Gornowicz A, Bielawski K, Noworól J, Mandziuk S, Wujec M. New 1,3,4-Thiadiazole Derivatives with Anticancer Activity. Molecules. 2022 Mar 10;27(6):1814. doi: 10.3390/molecules27061814. PMID: 35335177; PMCID: PMC8955053.
Hermanowicz JM, Szymanowska A, Sieklucka B, Czarnomysy R, Pawlak K, Bielawska A, Bielawski K, Kalafut J, Przybyszewska A, Surazynski A, Rivero-Muller A, Mojzych M, Pawlak D. Exploration of novel heterofused 1,2,4-triazine derivative in colorectal cancer. J Enzyme Inhib Med Chem. 2021 Dec;36(1):535-548. doi: 10.1080/14756366.2021.1879803. PMID: 33522320; PMCID: PMC7850456.
Gornowicz A, Szymanowski W, Bielawski K, Kałuża Z, Michalak O, Bielawska A. Mucin 1 as a Molecular Target of a Novel Diisoquinoline Derivative Combined with Anti-MUC1 Antibody in AGS Gastric Cancer Cells. Molecules. 2021 Oct 28;26(21):6504. doi: 10.3390/molecules26216504. PMID: 34770912; PMCID: PMC8588261.
Radziejewska I, Supruniuk K, Czarnomysy R, Buzun K, Bielawska A. Anti-Cancer Potential of Afzelin towards AGS Gastric Cancer Cells. Pharmaceuticals (Basel). 2021 Sep 25;14(10):973. doi: 10.3390/ph14100973. PMID: 34681197; PMCID: PMC8539446.
Gornowicz A, Szymanowski W, Czarnomysy R, Bielawski K, Bielawska A. Anti-HER2 monoclonal antibodies intensify the susceptibility of human gastric cancer cells to etoposide by promoting apoptosis, but not autophagy. PLoS One. 2021 Aug 26;16(8):e0255585. doi: 10.1371/journal.pone.0255585. PMID: 34437575; PMCID: PMC8389407.
Radziejewska I, Supruniuk K, Bielawska A. Anti-cancer effect of combined action of anti-MUC1 and rosmarinic acid in AGS gastric cancer cells. Eur J Pharmacol. 2021 Jul 5;902:174119. doi: 10.1016/j.ejphar.2021.174119. Epub 2021 Apr 27. PMID: 33930385.
Buzun K, Gornowicz A, Lesyk R, Bielawski K, Bielawska A. Autophagy Modulators in Cancer Therapy. Int J Mol Sci. 2021 May 28;22(11):5804. doi: 10.3390/ijms22115804. PMID: 34071600; PMCID: PMC8199315.
Buzun K, Kryshchyshyn-Dylevych A, Senkiv J, Roman O, Gzella A, Bielawski K, Bielawska A, Lesyk R. Synthesis and Anticancer Activity Evaluation of 5-[2-Chloro-3-(4-nitrophenyl)-2-propenylidene]-4-thiazolidinones. Molecules. 2021 May 20;26(10):3057. doi: 10.3390/molecules26103057. PMID: 34065476; PMCID: PMC8161026.
Radomska D, Czarnomysy R, Radomski D, Bielawska A, Bielawski K. Selenium as a Bioactive Micronutrient in the Human Diet and Its Cancer Chemopreventive Activity. Nutrients. 2021 May 13;13(5):1649. doi: 10.3390/nu13051649. PMID: 34068374; PMCID: PMC8153312.
Lendzion K, Gornowicz A, Bielawski K, Bielawska A. Phytochemical Composition and Biological Activities of Scorzonera Species. Int J Mol Sci. 2021 May 12;22(10):5128. doi: 10.3390/ijms22105128. PMID: 34066212; PMCID: PMC8151016.
Gornowicz A, Szymanowska A, Mojzych M, Czarnomysy R, Bielawski K, Bielawska A. The Anticancer Action of a Novel 1,2,4-Triazine Sulfonamide Derivative in Colon Cancer Cells. Molecules. 2021 Apr 2;26(7):2045. doi: 10.3390/molecules26072045. PMID: 33918514; PMCID: PMC8038278.
Buzun K, Bielawska A, Bielawski K, Gornowicz A. DNA topoisomerases as molecular targets for anticancer drugs. J Enzyme Inhib Med Chem. 2020 Dec;35(1):1781-1799. doi: 10.1080/14756366.2020.1821676. PMID: 32975138; PMCID: PMC7534307.
Sudoł S, Kucwaj-Brysz K, Kurczab R, Wilczyńska N, Jastrzębska-Więsek M, Satała G, Latacz G, Głuch-Lutwin M, Mordyl B, Żesławska E, Nitek W, Partyka A, Buzun K, Doroz-Płonka A, Wesołowska A, Bielawska A, Handzlik J. Chlorine substituents and linker topology as factors of 5-HT6R activity for novel highly active 1,3,5-triazine derivatives with procognitive properties in vivo. Eur J Med Chem. 2020 Oct 1;203:112529. doi: 10.1016/j.ejmech.2020.112529. Epub 2020 Jul 6. PMID: 32693296.
Gornowicz A, Szymanowska A, Mojzych M, Bielawski K, Bielawska A. The Effect of Novel 7-methyl-5-phenyl-pyrazolo[4,3-e]tetrazolo[4,5-b][1,2,4]triazine Sulfonamide Derivatives on Apoptosis and Autophagy in DLD-1 and HT-29 Colon Cancer Cells. Int J Mol Sci. 2020 Jul 23;21(15):5221. doi: 10.3390/ijms21155221. PMID: 32717981; PMCID: PMC7432848.
Ostrowska L, Gornowicz A, Pietraszewska B, Bielawski K, Bielawska A. Which salivary components can differentiate metabolic obesity? PLoS One. 2020 Jun 29;15(6):e0235358. doi: 10.1371/journal.pone.0235358. PMID: 32598403; PMCID: PMC7323955.
Czarnomysy R, Radomska D, Muszyńska A, Hermanowicz JM, Prokop I, Bielawska A, Bielawski K. Evaluation of the Anticancer Activities of Novel Transition Metal Complexes with Berenil and Nitroimidazole. Molecules. 2020 Jun 21;25(12):2860. doi: 10.3390/molecules25122860. PMID: 32575817; PMCID: PMC7355748.
Gornowicz A, Szymanowski W, Bielawska A, Szymanowska A, Czarnomysy R, Kałuża Z, Bielawski K. Monoclonal anti‑MUC1 antibody with novel octahydropyrazino[2,1‑a:5,4‑a']diisoquinoline derivative as a potential multi‑targeted strategy in MCF‑7 breast cancer cells. Oncol Rep. 2019 Oct;42(4):1391-1403. doi: 10.3892/or.2019.7256. Epub 2019 Aug 2. PMID: 31524251; PMCID: PMC6718100.
Czarnomysy R, Bielawska A, Bielawski K. Effect of 2nd and 3rd generation PAMAM dendrimers on proliferation, differentiation, and pro-inflammatory cytokines in human keratinocytes and fibroblasts. Int J Nanomedicine. 2019 Sep 3;14:7123-7139. doi: 10.2147/IJN.S211682. PMID: 31564869; PMCID: PMC6731979.
Czarnomysy R, Surażyński A, Muszynska A, Gornowicz A, Bielawska A, Bielawski K. A novel series of pyrazole-platinum(II) complexes as potential anti-cancer agents that induce cell cycle arrest and apoptosis in breast cancer cells. J Enzyme Inhib Med Chem. 2018 Dec;33(1):1006-1023. doi: 10.1080/14756366.2018.1471687. PMID: 29862867; PMCID: PMC6009892.
Pawłowska N, Gornowicz A, Bielawska A, Surażyński A, Szymanowska A, Czarnomysy R, Bielawski K. The molecular mechanism of anticancer action of novel octahydropyrazino[2,1-a:5,4-a']diisoquinoline derivatives in human gastric cancer cells. Invest New Drugs. 2018 Dec;36(6):970-984. doi: 10.1007/s10637-018-0584-y. Epub 2018 Mar 17. PMID: 29549610; PMCID: PMC6244973.
Jasiewicz B, Sierakowska A, Jankowski W, Hoffmann M, Piorońska W, Górnicka A, Bielawska A, Bielawski K, Mrówczyńska L. Antioxidant and cytotoxic activity of new di- and polyamine caffeine analogues. Free Radic Res. 2018 Jun;52(6):724-736. doi: 10.1080/10715762.2018.1467561. PMID: 29669446.
Radziejewska I, Borzym-Kluczyk M, Leszczyńska K, Wosek J, Bielawska A. Lotus tetragonolobus and Maackia amurensis lectins influence phospho-IκBα, IL-8, Lewis b and H type 1 glycoforms levels in H. pylori infected CRL-1739 gastric cancer cells. Adv Med Sci. 2018 Mar;63(1):205-211. doi: 10.1016/j.advms.2017.06.003. Epub 2017 Dec 1. PMID: 29197783.
Gornowicz A, Bielawska A, Szymanowski W, Gabryel-Porowska H, Czarnomysy R, Bielawski K. Mechanism of anticancer action of novel berenil complex of platinum(II) combined with anti-MUC1 in MCF-7 breast cancer cells. Oncol Lett. 2018 Feb;15(2):2340-2348. doi: 10.3892/ol.2017.7623. Epub 2017 Dec 14. PMID: 29434943; PMCID: PMC5776928.
Branowska D, Ławecka J, Sobiczewski M, Karczmarzyk Z, Wysocki W, Wolińska E, Olender E, Mirosław B, Perzyna A, Bielawska A, Bielawski K. Synthesis of unsymmetrical disulfanes bearing 1,2,4-triazine scaffold and their in vitro screening towards anti-breast cancer activity. Monatsh Chem. 2018;149(8):1409-1420. doi: 10.1007/s00706-018-2206-y. Epub 2018 Jun 27. PMID: 30100632; PMCID: PMC6060961.
Kapron B, Czarnomysy R, Paneth A, Wujec M, Bielawski K, Bielawska A, Swiatek L, Rajtar B, Polz-Dacewicz M, Plech T. Dual Antibacterial and Anticancer Activity of 4-Benzoyl-1-dichlorobenzoylthiosemicarbazide Derivatives. Anticancer Agents Med Chem. 2018;18(4):529-540. doi: 10.2174/1871520617666171023142958. PMID: 29065843.
Bielawski K, Leszczyńska K, Kałuża Z, Bielawska A, Michalak O, Daniluk T, Staszewska-Krajewska O, Czajkowska A, Pawłowska N, Gornowicz A. Synthesis and antimicrobial activity of chiral quaternary N-spiro ammonium bromides with 3',4'-dihydro-1'H-spiro[isoindoline-2,2'-isoquinoline] skeleton. Drug Des Devel Ther. 2017 Jul 5;11:2015-2028. doi: 10.2147/DDDT.S133250. PMID: 28740363; PMCID: PMC5503491.
Gornowicz A, Pawłowska N, Czajkowska A, Czarnomysy R, Bielawska A, Bielawski K, Michalak O, Staszewska-Krajewska O, Kałuża Z. Biological evaluation of octahydropyrazin[2,1-a:5,4-a']diisoquinoline derivatives as potent anticancer agents. Tumour Biol. 2017 Jun;39(6):1010428317701641. doi: 10.1177/1010428317701641. PMID: 28618951.
Czarnomysy R, Surażyński A, Popławska B, Rysiak E, Pawłowska N, Czajkowska A, Bielawski K, Bielawska A. Synergistic action of cisplatin and echistatin in MDA-MB-231 breast cancer cells. Mol Cell Biochem. 2017 Mar;427(1-2):13-22. doi: 10.1007/s11010-016-2894-8. Epub 2016 Dec 19. PMID: 27995416; PMCID: PMC5306075.
Czajkowska A, Gornowicz A, Pawłowska N, Czarnomysy R, Nazaruk J, Szymanowski W, Bielawska A, Bielawski K. Anticancer Effect of a Novel Octahydropyrazino[2,1-a:5,4-a']diisoquinoline Derivative and Its Synergistic Action with Nigella sativa in Human Gastric Cancer Cells. Biomed Res Int. 2017;2017:9153403. doi: 10.1155/2017/9153403. Epub 2017 Dec 26. PMID: 29441354; PMCID: PMC5758943.
Czarnomysy R, Bielawski K, Muszynska A, Bielawska A, Gornowicz A. Biological evaluation of dimethylpyridine-platinum complexes with potent antiproliferative activity. J Enzyme Inhib Med Chem. 2016;31(sup3):150-165. doi: 10.1080/14756366.2016.1212191. Epub 2016 Aug 4. PMID: 27488500.
Plech T, Kaproń B, Paneth A, Wujec M, Czarnomysy R, Bielawska A, Bielawski K, Trotsko N, Kuśmierz E, Paneth P. Search for human DNA topoisomerase II poisons in the group of 2,5-disubstituted-1,3,4-thiadiazoles. J Enzyme Inhib Med Chem. 2015 Dec;30(6):1021-6. doi: 10.3109/14756366.2014.995179. Epub 2015 Sep 4. PMID: 25792499.
Gornowicz A, Bielawska A, Czarnomysy R, Gabryel-Porowska H, Muszyńska A, Bielawski K. The combined treatment with novel platinum(II) complex and anti-MUC1 increases apoptotic response in MDA-MB-231 breast cancer cells. Mol Cell Biochem. 2015 Oct;408(1-2):103-13. doi: 10.1007/s11010-015-2486-z. Epub 2015 Jun 27. PMID: 26112902; PMCID: PMC4768227.
Czarnomysy R, Bielawska A, Muszyńska A, Bielawski K. Effects of novel alkyl pyridine platinum complexes on apoptosis in Ishikawa endometrial cancer cells. Med Chem. 2015;11(6):540-50. doi: 10.2174/1573406411666150206163547. PMID: 25659127.
Lepiarczyk M, Kałuża Z, Bielawska A, Czarnomysy R, Gornowicz A, Bielawski K. Cytotoxic activity of octahydropyrazin[2,1-a:5,4-a']diisoquinoline derivatives in human breast cancer cells. Arch Pharm Res. 2015;38(5):628-41. doi: 10.1007/s12272-014-0444-z. Epub 2014 Jul 25. PMID: 25060945.
Gornowicz A, Kałuża Z, Bielawska A, Gabryel-Porowska H, Czarnomysy R, Bielawski K. Cytotoxic efficacy of a novel dinuclear platinum(II) complex used with anti-MUC1 in human breast cancer cells. Mol Cell Biochem. 2014 Jul;392(1-2):161-74. doi: 10.1007/s11010-014-2018-2. Epub 2014 Mar 18. PMID: 24639126; PMCID: PMC4053609.
Gornowicz A, Tokajuk G, Bielawska A, Maciorkowska E, Jabłoński R, Wójcicka A, Bielawski K. The assessment of sIgA, histatin-5, and lactoperoxidase levels in saliva of adolescents with dental caries. Med Sci Monit. 2014 Jun 29;20:1095-100. doi: 10.12659/MSM.890468. PMID: 24974109; PMCID: PMC4087079.